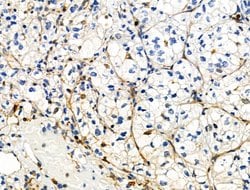
Invitrogen Phospho-ZO-2 (Tyr1118) Polyclonal Antibody 100 &mu;L | Buy Online | Invitrogen&trade; | Fisher Scientific

missing translation for 'onlineSavingsMsg'
Learn More
Learn More
Invitrogen™ Phospho-ZO-2 (Tyr1118) Polyclonal Antibody


Description
Antibody detects endogenous levels of ZO-2 only when phosphorylated at Tyr1118.
CD45 (LCA, leukocyte common antigen) is a receptor-type protein tyrosine phosphatase (PTP) ubiquitously expressed in all nucleated hematopoietic cells, comprising approximately 10% of all surface proteins in lymphocytes. CD45 is absent on non-hematopoietic cell lines, normal and malignant, non-hematopoietic tissues. CD45 glycoprotein is crucial in lymphocyte development and antigen signaling, serving as an important regulator of Src-family kinases. CD45 protein exists as multiple isoforms as a result of alternative splicing, differ in their extracellular domains but share identical transmembrane and cytoplasmic domains. CD45RA is an isoform of the CD45 complex and has restricted expression between different subtypes of lymphoid cells. CD45 isoforms differ in their ability to translocate into the glycosphingolipid-enriched membrane domains and their expression depends on cell type and physiological state of the cell. CD45 has been shown to be an essential regulator of T- and B-cell antigen receptor signaling and suppresses JAK kinases to regulate cytokine receptor signaling. CD45 is also important in promoting cell survival by modulating integrin-mediated signal transduction pathway, DNA fragmentation during apoptosis and inhibition or upregulation of various immunological functions.
Spécifications
Spécifications
| Antigen | Phospho-ZO-2 (Tyr1118) |
| Applications | Immunohistochemistry (Paraffin), Western Blot |
| Classification | Polyclonal |
| Concentration | 1 mg/mL |
| Conjugate | Unconjugated |
| Formulation | PBS with 50% glycerol and 0.02% sodium azide |
| Gene | TJP2 |
| Gene Accession No. | Q9UDY2, Q9Z0U1 |
| Gene Alias | C9DUPq21.11; DFNA51; DUP9q21.11; Friedreich ataxia region gene X104 (tight junction protein ZO-2); PFIC4; tight junction protein; tight junction protein 2; tight junction protein 2 (zona occludens 2); tight junction protein ZO-2; Tight junction protein ZO-2 (Zonula occludens 2 protein) (Zona occludens 2 protein) (Tight junction protein 2); Tjp2; X104; ZO2; ZO-2; zona occludens 2; zona occludens protein 2; Zonula occludens protein 2 |
| Gene Symbols | TJP2 |
| Afficher plus de résultats |